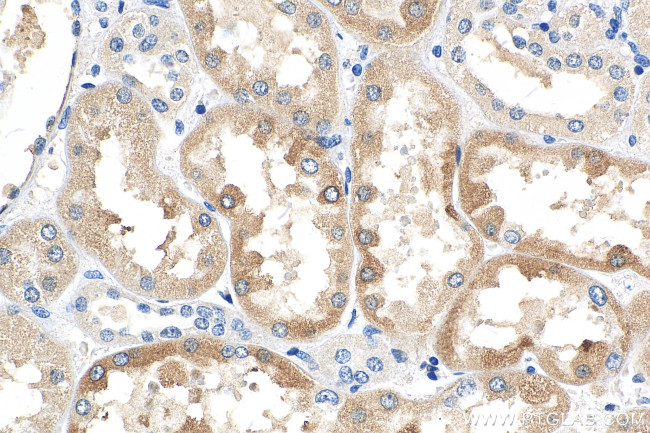
FATP2 Antibody in Immunohistochemistry (Paraffin) (IHC (P))

Search
Proteintech
FATP2 Monoclonal Antibody (2C10D7)
{{$productOrderCtrl.translations['antibody.pdp.commerceCard.promotion.promotions']}}
{{$productOrderCtrl.translations['antibody.pdp.commerceCard.promotion.viewpromo']}}
{{$productOrderCtrl.translations['antibody.pdp.commerceCard.promotion.promocode']}}: {{promo.promoCode}} {{promo.promoTitle}} {{promo.promoDescription}}. {{$productOrderCtrl.translations['antibody.pdp.commerceCard.promotion.learnmore']}}
产品信息
68074-1-IG
种属反应
宿主/亚型
分类
类型
克隆号
抗原
偶联物
形式
纯化类型
保存液
内含物
保存条件
运输条件
产品详细信息
Immunogen sequence: ESWRSEVTFS TPALYIYTSG TTGATLALRT KFSASQFWDD CRKYNVTVIQ YIGELLRYLC NSPQKPNDRD HKVRLALGNG LRGDVWRQFV KRFGDICIYE FYAATEGNIG FMNYARKVGA VGRVNYLQKK IITYDLIKYD VEKDEPVRDE NGYCVRVPKG EVGLLVCKIT QLTPFNGYAG AKAQTEKKKL RDVFKKGDLY FNSGDLLMVD HENFIYFHDR VGDTFRWKGE NVATTEVADT VGLVDFVQEV NVYGVHVPDH EGRIGMASIK MKENHEFDGK KLFQHIADYL PSYARPRFLR IQDTIEITGT FKHRKMTLVE EGFNPAVIKD ALYFLDDTAK MYVPMTEDIY NAISAKTLKL
靶标信息
The protein encoded by this gene is an isozyme of long-chain fatty-acid-coenzyme A ligase family. Although differing in substrate specificity, subcellular localization, and tissue distribution, all isozymes of this family convert free long-chain fatty acids into fatty acyl-CoA esters, and thereby play a key role in lipid biosynthesis and fatty acid degradation. This isozyme activates long-chain, branched-chain and very-long-chain fatty acids containing 22 or more carbons to their CoA derivatives. It is expressed primarily in liver and kidney, and is present in both endoplasmic reticulum and peroxisomes but not in mitochondria. Its decreased peroxisomal enzyme activity is in part responsible for the biochemical pathology in X-linked adrenoleukodystrophy.
仅用于科研。不用于诊断过程。未经明确授权不得转售。
篇参考文献 (0)
生物信息学
蛋白别名: Arachidonate--CoA ligase; FATP-2; Fatty acid transport protein 2; Fatty-acid-coenzyme A ligase, very long-chain 1; Long-chain fatty acid transport protein 2; Long-chain-fatty-acid--CoA ligase; Phytanate--CoA ligase; solute carrier family 27 (fatty acid transporter), member 2; solute carrier family 27 (fatty acid transporter), member 32; Solute carrier family 27 member 2; THCA-CoA ligase; unnamed protein product; ve; Very long-chain acyl-CoA synthetase; very long-chain fatty-acid-coenzyme A ligase 1; Very long-chain-fatty-acid-CoA ligase; VLACS; VLCS
基因别名: ACSVL1; FACVL1; FATP2; hFACVL1; HsT17226; SLC27A2; VLACS; VLCS
UniProt ID: (Human) O14975, (Rat) P97524
Entrez Gene ID: (Human) 11001, (Rat) 65192